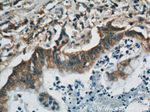
RBBP9 Antibody in Immunohistochemistry (Paraffin) (IHC (P))

Search
Proteintech
RBBP9 Monoclonal Antibody (3D5E11)
{{$productOrderCtrl.translations['antibody.pdp.commerceCard.promotion.promotions']}}
{{$productOrderCtrl.translations['antibody.pdp.commerceCard.promotion.viewpromo']}}
{{$productOrderCtrl.translations['antibody.pdp.commerceCard.promotion.promocode']}}: {{promo.promoCode}} {{promo.promoTitle}} {{promo.promoDescription}}. {{$productOrderCtrl.translations['antibody.pdp.commerceCard.promotion.learnmore']}}
产品信息
66015-2-IG
种属反应
宿主/亚型
分类
类型
克隆号
抗原
偶联物
形式
浓度
规格
纯化类型
保存液
内含物
保存条件
运输条件
产品详细信息
Immunogen sequence: MASPSKAVI VPGNGGGDVT THGWYGWVKK ELEKIPGFQC LAKNMPDPIT ARESIWLPFM ETELHCDEKT IIIGHSSGAI AAMRYAETHR VYAIVLVSAY TSDLGDENER ASGYFTRPWQ WEKIKANCPY IVQFGSTDDP FLPWKEQQEV ADRLETKLHK FTDCGHFQNT EFHELITVVK SLLKVPA (1-186 aa encoded by BC015938)
靶标信息
RBBP9 may play a role in the transformation process due to its capacity to confer resistance to the growth-inhibitory effects of TGF-beta1 through interaction with retinoblastoma and the subsequent displacement of E2F-1.The protein encoded by this gene is a retinoblastoma binding protein that may play a role in the regulation of cell proliferation and differentiation. Two alternatively spliced transcript variants of this gene with identical predicted protein products have been reported, one of which is a nonsense-mediated decay candidate.
仅用于科研。不用于诊断过程。未经明确授权不得转售。
篇参考文献 (0)
生物信息学
蛋白别名: B5T overexpressed gene protein; B5T-overexpressed gene protein; MGC9236; Protein BOG; putative hydrolase RBBP9; RBBP-10; RBBP-9; Retinoblastoma-binding protein 10; Retinoblastoma-binding protein 9; retinoma-binding protein 9; Serine hydrolase RBBP9
基因别名: BOG; RBBP10; RBBP9
UniProt ID: (Human) O75884, (Rat) O88350, (Mouse) O88851
Entrez Gene ID: (Human) 10741, (Pig) 100738866, (Rat) 29459, (Mouse) 26450